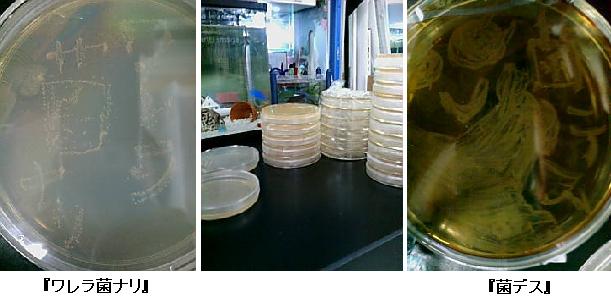
999.JPG

PR
Keyword Search
Calendar
Comments
Freepage List


5/10 久々の夜遊びはイィですねぇ~
1時に出発帰ってきたのは朝6時↓↓
この日はすでに1日徹夜した後だったので結構キツかった…。
5/11 2日連続の徹夜、相当キてます…。
立ったまま寝てしまうありさま・・・(ホントに)
今日はシッカリ寝よう と思いながら
また出かけてしまいました

あ、ちなみにクワガタは逃がしました…。

実験の予定が立たず、精神的に参ってる今日この頃。。。
しかしそこに追い打ちをかけるかの如く続く悩ましい事…↓↓
もぅ私は疲れたわ![]()
5/12 菌の継代をする。
クリーンベンチ内に3時間以上ぶっ通しは終いにゃ、うつになりそぉになる
だからってこんな事をして…
もぉ…、見つかったら抹殺されるやんねぇ。。。
と思いながら先生が横におるのに写真撮りよるしww
**********************
ここで一言
『休みをくれ』